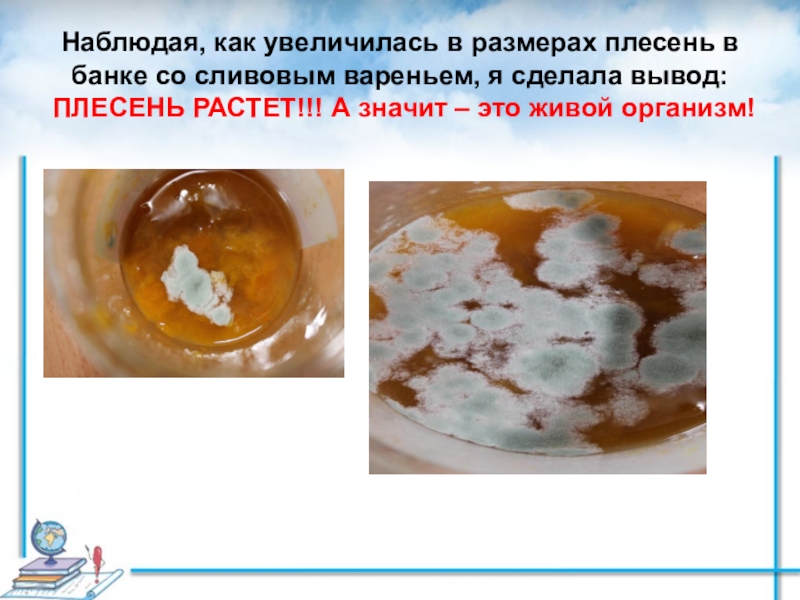
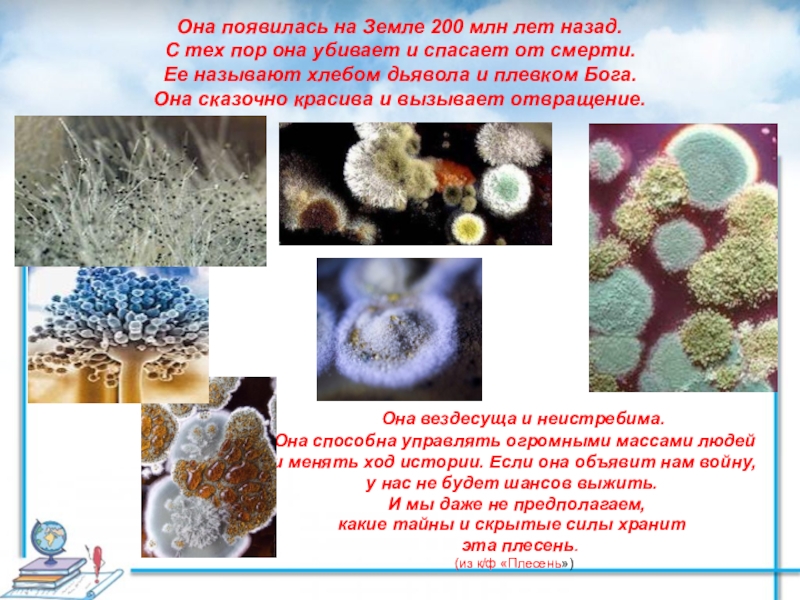

- Главная
- Разное
- Образование
- Спорт
- Естествознание
- Природоведение
- Религиоведение
- Французский язык
- Черчение
- Английский язык
- Астрономия
- Алгебра
- Биология
- География
- Геометрия
- Детские презентации
- Информатика
- История
- Литература
- Математика
- Музыка
- МХК
- Немецкий язык
- ОБЖ
- Обществознание
- Окружающий мир
- Педагогика
- Русский язык
- Технология
- Физика
- Философия
- Химия
- Шаблоны, фоны, картинки для презентаций
- Экология
- Экономика
Презентация, доклад на тему Плесень – это опасная или добрая соседка? презентация
Содержание
- 1. Плесень – это опасная или добрая соседка? презентация
- 2. Содержание работы 1.Введение 2.Цель работы, задачи,
- 3. С чего все началось…Плесень выросла в закрытой
- 4. Цельузнать о плесени как можно больше и
- 5. Чтобы упростить описание живого мира, учёные объединили
- 6. Наблюдая, как увеличилась в размерах
- 7. Признаки живых организмов
- 8. Плесень относится к царству грибов. Во-первых, питается
- 9. Мой экспериментЦель: определить условия образования и роста
- 10. Слайд 10
- 11. Слайд 11
- 12. Вывод: из данного эксперимента следует, что главным
- 13. Условия появления и развития плесенивлажностьтемпература выше + 20 Сотсутствие вентиляции
- 14. Она появилась на Земле 200 млн лет
- 15. На месте аварии Чернобыльской АЭС было обнаружено
- 16. В 1928 году шотландский микробиолог Александр Флеминг
- 17. Слайд 17
- 18. Социологический опрос учащихся 2 А класса.1.Видели ли Вы когда-нибудь плесень?
- 19. 2.Знаете ли Вы что такое плесень?
- 20. 3.Вредна или полезна плесень для человека?Исходя из
- 21. Мои выводыБлагодаря своей работе я сделала выводы:
- 22. Заключение *Плесень - это грибы.
- 23. Список источников1. Энциклопедия «Я познаю мир. Ботаника».
Слайд 1Плесень – это опасная или добрая соседка?
Выполнила: Калабухова Александра
ученица 2 «А»
Руководитель: Батова Татьяна Григорьевна
учитель начальных классов
2016 год
Слайд 2Содержание работы
1.Введение
2.Цель работы, задачи, гипотезы
3.Описание проведения опытов
4.Результаты исследования,
5.Отрицательные и положительные стороны плесени
6.Социологический опрос
7.Заключение
8.Приложения (фото, рисунки, таблица, диск, фотоальбом)
9.Список источников
Слайд 3С чего все началось…
Плесень выросла в закрытой банке со сливовым вареньем,
Слайд 4Цель
узнать о плесени как можно больше и вырастить её в домашних
Задачи
узнать, что такое плесень, получить новые знания в процессе выполнения работы;
узнать: вред или пользу она приносит людям;
попытаться «вырастить» плесень в домашних условиях на продуктах питания (на хлебе);
исследовать причины появления плесени на продуктах питания, а именно на хлебе;
выяснить, как предотвратить порчу продуктов;
сделать вывод;
составить презентацию
Гипотеза
Методы исследования
плесень относится к царству грибов и лучше развивается в теплой и влажной среде.
Работа с научной,
художественной литературой и Интернет-ресурсами, посмотрела фильм о плесени.
Практическое исследование.
Слайд 5Чтобы упростить описание живого мира, учёные объединили живые существа в группы
Царство животных
Слайд 6 Наблюдая, как увеличилась в размерах плесень в банке со сливовым вареньем,
Слайд 8Плесень относится к царству грибов. Во-первых, питается готовыми органическими веществами, во-вторых:
Плесень – простонародное название грибка. Бывает плесневым (растет на камне, бетоне, краске), грибком синевы (растет в клетчатке дерева), грибком гниения (бактериальная, белая, бурая), дрожжевым грибком.
Слайд 9Мой эксперимент
Цель: определить условия образования и роста плесени.
Оборудование: 4 кусочка
Описание: я взяла 4 кусочка белого хлеба.
Первый – положила на тарелку и поставила на стол (температура воздуха +24);
Второй – положила в холодильник (температура +5 градусов);
Третий – поместила в пакет и тоже разместила на столе;
Четвертый - намочила чуть-чуть водой и положила в банку с закрытой крышкой, в теплое место (+28 градусов).
Слайд 12Вывод: из данного эксперимента следует, что главным условием появления и роста
Слайд 14Она появилась на Земле 200 млн лет назад. С тех пор
Она вездесуща и неистребима.
Она способна управлять огромными массами людей
и менять ход истории. Если она объявит нам войну,
у нас не будет шансов выжить.
И мы даже не предполагаем,
какие тайны и скрытые силы хранит
эта плесень.
(из к/ф «Плесень»)
Слайд 15На месте аварии Чернобыльской АЭС было обнаружено огромное количество плесени. Она
Споры плесневых грибов прикрепили к обшивке космического корабля, летавшего в космосе. Через полтора года выяснилось: в условиях безвоздушного пространства «испытуемые» выжили, стали еще агрессивнее и устойчивее. Возможно, поражения, нанесенные плесенью аппаратуре орбитальной станции «Мир», были одной из причин ее затопления.
Слайд 16В 1928 году шотландский микробиолог Александр Флеминг открыл антибиотик – пенициллин,
Слайд 203.Вредна или полезна плесень для человека?
Исходя из моего опроса, я сделала
Слайд 21Мои выводы
Благодаря своей работе я сделала выводы:
- Нужно регулярно делать
- Проветривать комнату.
- Нельзя принимать в пищу повреждённые плесенью продукты.
И узнала:
- Плесень является живым организмом.
- Плесень относится к царству грибов.
Выяснила, какие условия нужны для её роста.
Слайд 22Заключение
*Плесень - это грибы.
*При условиях влажности,
* Плесень может причинить вред, став причиной болезни, но она несет и благо – формирует почву, дает нам вино, сыр, хлеб, лечит нас от болезни.
Моя гипотеза подтвердилась!
Слайд 23Список источников
1. Энциклопедия «Я познаю мир. Ботаника». Автор Ю.Н. Касаткина «Астрель».
2. Универсальная энциклопедия школьника «Биология и Анатомия» Минск ТОО «Харвест» 1995 г. составитель А.А. Воротников.
3. Научно-популярный журнал «Наука и жизнь» №10 2009 г.
4. Справочник терапевта. Грибковые заболевания. «Издательство АСТ» 1998 г.